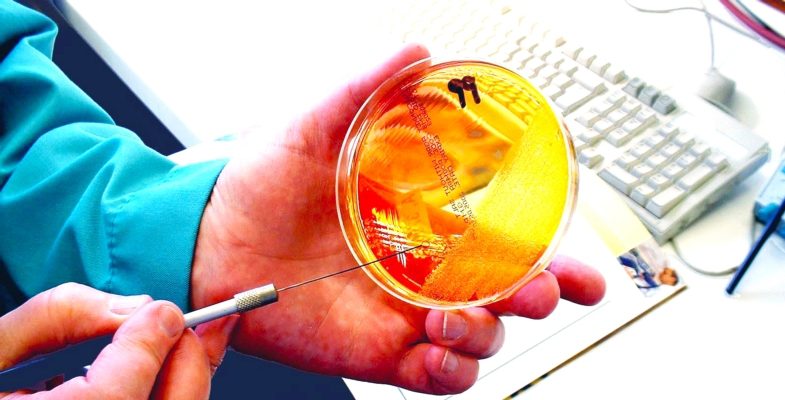

Laboratório Golabek
Análises Clínicas
Há 35 anos atuando em análises clínicas, auxiliando no diagnóstico clínico com qualidade e confiabilidade nos resultados.
Prezamos pela excelência no atendimento, satisfação e comodidade de nossos clientes e sobretudo o respeito à vida humana.